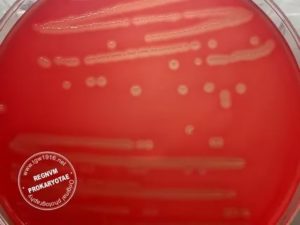
image
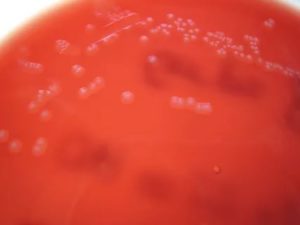
image

Род стрептококков насчитается более 100 различных типов микробов. Некоторые из них – это представители условно-патогенной микрофлоры, другая часть – провоцирует болезнь (стрептококковую инфекцию).
Сами микроорганизмы характеризуются микроскопическим размером, шаровидной формой, хорошо переносят низкий температурный режим.
При отсутствии жалоб стрептококк у мужчин не является признаком патологического процесса.
В большинстве клинических картин повышенная активность и размножение стрептококков у мужчин в уретральном канале приводят к клиническим проявлениям баланита либо баланопостита.
Головка репродуктивного органа выглядит воспаленной, краснеет, крайняя плоть отечная, значительно утолщается.
Иногда присутствуют мелкозернистые высыпания в виде мелких пузырьков красного цвета, выделения из уретры.
Обильная сыпь, раздражение сопровождаются сильнейшим жжением не только полового органа, но и уретры. При опорожнении мочевого пузыря мужчины испытывает боль, достаточно выраженный дискомфорт. В некоторых случаях болевой синдром распространяется на подвздошную зону.
К сведению, если стрептококковая инфекция у мужчин поразила предстательную железу, то выявляются сильные боли в яичках, затрудненное и учащенное мочеиспускание.
Стрептококки у мужчин редко сопровождаются интоксикацией организма. Как правило, интоксикация выявляется при тонзиллите, ангине, фарингите и др. заболеваниях, позволяющих условно-патогенному возбудителю распространяться с током крови и лимфатической жидкости по организму.
К симптомам интоксикации относят такие признаки:
- Лихорадочное состояние;
- Высокая температура тела;
- Вялость, слабость;
- Тошнота (рвота – крайне редко);
- Общее недомогание.
Если у пациента диагностирован тонзиллит либо фарингит стрептококковой природы, то это значительный фактор риска развития заболевания др. органов и внутренних систем. Особенно это касается состояний на фоне низкого иммунитета, дефицита витаминов. У мальчиков подросткового возраста инфекция мочеполовых путей развивается вследствие несоблюдения правил гигиены.
Микрофлора уретры у мужчин не обусловлена возрастом человека, однако видоизменяется под воздействием ряда провоцирующих факторов. Некоторые агенты населяют мочеиспускательный канал постоянно, а некоторые присутствуют в течение короткого периода времени. В отличие от женской мужская микрофлора не характеризуется какими-либо специфическими функциями.
В медицинской практике отдельно выделяется транзиторная микрофлора (другое название – условно-патогенная). К ней относят бактерии, которые при благоприятных обстоятельствах активизируются, что приводит к развитию заболевания. Обычно микробы «живут» в уретре небольшое время, поскольку успешно нивелируются защитными механизмами мужского организма:
- Механическая защита представлена заслонкой Герена.
- Слабощелочная среда губительно действует на некоторых микробов.
- Иммунологическая защита обусловлена активностью определенных клеток, которые продуцируются предстательной железой и слизистой оболочкой мочеиспускательного канала.
Основная причина заражения стрептококком – половой путь, в том числе оральный либо анальный контакт. К другим вариантам относят вертикальный путь – когда инфекция передается от матери к ребенку при рождении. Можно заразиться при переливании крови либо трансплантации органов.
Стоит знать: стрептококковая инфекция мочеполовой системы у мужчин приводит к различным патологиям – воспаление уретры (уретрит) или крайней плоти (баланопостит), предстательной железы (простатит), придатков яичек (эпидидимит) и пр.
Стрептококк в уретре начинает активно размножаться под воздействием следующих факторов:
- Снижение иммунного статуса на фоне хронических заболеваний, иммунодефицита;
- Хронический простатит. Медики отмечают, что активизация транзиторной микрофлоры обусловлена снижением уровня цинка в простатическом соке;
- Половые инфекции в анамнезе, которые спровоцировали рубцевание слизистой половых органов, что нарушило местный иммунитет;
- Ожог мочеиспускательного канала вследствие применения антисептиков и пр.
При наличии характерных признаков врач назначает обследование пациента. Лечение рекомендуется после установления вида возбудителя, его активности, также учитывают клинические проявления у мужчины.
В настоящий момент выявлено более ста разновидностей стрептококков, каждый из которых характеризуется определенной патогенностью. Для удобства данное семейство микробов классифицируется в соответствии с гемолизом эритроцитов. Гемолиз – это разрушение эритроцитов в крови с последующим выделением гемоглобина в окружающую среду.
Важно: в соответствии с классификацией Брауна выделяются альфа-стрептококки – микроорганизмы, приводящие к неполному гемолизу; бета-стрептококки – бактерии, вызывающие абсолютный гемолиз – предстают наиболее патогенными; гамма-стрептококки – микробы, активность которых не приводит к разрушению эритроцитов.
Данная разновидность патогенных микроорганизмов считается менее опасной, если сравнивать со стрептококками бета. В данную группу микробов относят следующие разновидности:
- Пневмококки. Эти агенты провоцируют развитие пневмонии, менингита, бронхита, ларингита, среднего отита, ринита, сепсиса и др. патологий. Оседают в дыхательных путях человека.
- Термофильные стрептококки – полезные микробы, которые применяются в пищевой промышленности для изготовления молочных продуктов, сыров, ряженки и пр.
- Мутанс бактерии приводят к кариесу зубов, характеризуются свойством плотно прилипать к зубной эмали.
- Слюнные стрептококки, как правило, живут во рту человека и верхних путях дыхания – нос, горло. Обладают свойством преобразовывать сахарозу в молочную кислоту. Некоторые штаммы таких микробов применяются в качестве пробиотиков.
- Streptococcus sanguis – «традиционный» обитатель налета на зубах, но имеет интересное качество, он не позволяет микробам мутанс прилипать к зубной эмали.
К альфа-гемолитическим стрептококкам относят разновидность Streptococcus mitis. Они оседают в верхних путях дыхания – носовые ходы, ротовая полость и горло. Это тип микроорганизмов, которые приводят к патологиям сердечно-сосудистой системы, например, инфекционный эндокардит.
Данная категория бактерий характеризуется высокой степенью опасности. Это обусловлено способностью микробов разрушать эритроциты. При этом в ходе своей жизнедеятельности микроорганизмы выделяют много токсичных компонентов, которые быстро распространяются по мужскому организму, приводя к серьезным болезням. В некоторых случаях на фоне отсутствия адекватного лечения – летальный исход.
Наиболее распространенные бета-стрептококки:
- Streptococcus pyogenes, dysgalactiae subsp. Эта группа микробов способствует развитию ангины, фарингита, цистита, бактериального вагинита и пр. патологий;
- Стрептококк агалактия у мужчин. Бактерия поражает желудочно-кишечный тракт и мочеполовую систему, приводит к инфекционным патологиям;
- Streptococcus equi и zooepidemicus не активизируются в человеческом организме, поражают исключительно животных;
- Streptococcus faecalis и faecies приводят к сепсису, но в настоящий момент переведены в группу энтерококков.
Примечание: стрептококки бета в ходе своей жизнедеятельности выделяют стрептолизин – компонент, способствующий разрушению клеток крови; лейкоцидин – ферментное вещество, разрушающее кровяные иммунные клетки и др. яды, которые отравляют организм.
Целесообразность лечения стрептококка агалактия у мужчин определяется самочувствием пациента и клиническими проявлениями. Если больной не жалуется на ухудшение состояния, то рекомендуется выжидательная тактика. Нередко в ходе носительства наблюдается самопроизвольное уничтожение инфекции.
Когда диагностировали стрептококков в мазке на фоне тревожных признаков, то используются антибактериальные препараты. В большинстве картин назначают лекарства пенициллинового ряда, фторхинолоны. При назначении терапевтического курса принимают во внимание вероятность смешанного инфекционного процесса. В этой картине требуется одновременный прием нескольких медикаментозных препаратов.
В качестве дополнительных способов лечения доктор может рекомендовать следующее:
- Физиотерапевтические процедуры;
- Массирование железистого органа;
- Прием иммуномодуляторов и иммуностимуляторов;
- Применение ферментных медикаментов;
- Народные средства;
- Местная терапия (в мочеиспускательный канал вводят специализированные растворы).
Отсутствие лечения стрептококковой инфекции у мужчин приводит к различным осложнениям – бесплодие, снижение эректильной функции и потенции, потеря полового влечения. Не исключается распространение воспалительного процесса на другие внутренние органы и мягкие ткани.
Медикаментозное лечение можно комбинировать с народными средствами, которые обладают антибактериальным эффектом, ориентированы на усиление иммунного статуса. Лук и чеснок – это природные антибиотики, обладающие высокой эффективностью в отношении различных инфекций в организме. Достаточно употреблять по 30-50 г два раза в день вместе с другими продуктами.
К результативным народным средствам относят:
- Черная смородина. В день нужно съедать 600 г, разделив на три равные порции;
- Отвар на основе шиповника без сахара. Принимают по 150 мл два раза в сутки;
- Отвар с добавлением череды помогает бороться с бактериями. Для приготовления берут 400 мл кипятка и столовую ложку компонента. Настаивают несколько часов, принимают по 100 мл 4 раза в сутки.
Отзывы отмечают, что свежие абрикосы эффективно борются со стрептококковой инфекцией мочеполовой системы. Фрукты кушают два раза в сутки – утреннее и вечернее время, только на голодный желудок.
Чтобы не допустить развитие осложнений стрептококковой инфекции, нужно бороться с ней не только лекарственными препаратами и народными средствами, но и осуществлять профилактические мероприятия.
Меры профилактики:
- Тщательное соблюдение правил гигиены – часто мыть руки, чистить зубы, садится кушать только с мытыми руками.
- Влажная уборка в жилых помещениях не меньше 2-х раз в неделю.
- Исключить переохлаждение организма.
- Своевременное лечение любых заболеваний дыхательных путей – ангина, фарингит, тонзиллит и пр.
- Обогащение рациона продуктами, которые изобилуют витаминами, минеральными компонентами и др. полезными веществами.
Важно: если дома есть больной со стрептококковой инфекцией, то ему нужно отдельно выделить столовые приборы, постельное белье, полотенце и пр. предметы личной гигиены.
При наличии характерных признаков нужно обратиться в медицинское учреждение. Если проблемы наблюдаются у мальчика школьного или подросткового возраста, то требуется посетить педиатра. Взрослый человек обращается к терапевту, инфекционисту либо урологу.
Источник: https://ManExpert.ru/zppp/streptokokk-u-muzhchin.html
Стрептококки агалактия (streptococcus agalactiae) – микроорганизмы семейства Стрептококковые. Они являются условно-патогенной разновидностью бактерий. Микроорганизмы в небольшом объеме могут существовать в теле человека, не угрожая при этом здоровью. Бактерии обитают в органах мочевыделительной и половой систем. Стрептококки агалактия имеют форму шара или овала.
Проникая в организм, размещаются парно, в виде цепочки. При нарушении нормального баланса микрофлоры концентрация стрептококков агалактия начинает стремительно увеличиваться, провоцируя острые воспалительные процессы.
Существует более 40 видов стрептококков.
Их объединяют в 4 основные группы:
Стрептококк агалактия принадлежит к группе бета-гемолитических стрептококков. Впервые он был обнаружен у коров, больных маститом.
Микроорганизм обитает преимущественно в урогенитальном тракте, прямой кишке и верхнем отделе глотки. Инфицирование происходит чаще всего половым путем. Другими способами заражения являются:
У мужчин заражение streptococcus agalactiae происходит при незащищенном сексе или снижении защитных сил организма.
У женщин активация патогенных микроорганизмов наблюдается при:
Причиной роста и размножения стрептококков агалактия у представителей обоих полов может быть также сахарный диабет.
Инфицирование происходит чаще всего во время прохождения по родовым путям, реже – при контакте с матерью или персоналом роддома.
Предрасполагающими к развитию стрептококковой инфекции у грудного ребенка являются определенные факторы:
Иногда заражение происходит внутриутробно.
Инфицирование возможно при выполнении диагностических и лечебных манипуляций:
Заражение стрептококком агалактия в подобных случаях – результат несоблюдения правил асептики.
При увеличении количества условно-патогенных бактерий в женском организме, развивается определенная симптоматика.
Основными проявлениями воспалительного процесса становятся:
Чрезмерная концентрация streptococcus agalactiae в мазке у женщин (более чем 10*5 КОЕ/мл) обычно указывает на цистит или вульвовагинит.
Патологический процесс, спровоцированный стрептококками агалактия, у мужчин вызывает чаще всего воспаление мочеиспускательного канала и мочевого пузыря.
Основные проявления:
У мужчин может наблюдаться также небольшое воспаление и выделения с гнойным содержимым из полового члена.
В период вынашивания ребенка происходит перестройка гормонального фона женщины. Увеличивается концентрация прогестерона, снижается иммунитет. В результате возможно обострение различных инфекций органов мочеполовой системы.
В группе повышенного риска по развитию патологического состояния находятся:
Частым осложнением воспалительного процесса, спровоцированного условно-патогенными бактериями, является послеродовой эндометрит.
Обследование беременных с повышенным риском развития инфекции или уже имеющих ее включает:
Диагностика выполняется на последнем месяце беременности. К этому сроку концентрация бактерий достигает наибольшего количества.
Диагностирование воспалительного процесса у мужчин и женщин объединяет лабораторные и инструментальные способы.
Главные исследования:
Комплексное обследование помогает специалисту определить диагноз и подобрать адекватное лечение.
Лечение стрептококка агалактия выполняется антибиотиками. Курс терапии продолжается не менее 5 дней.
Эффективными препаратами являются:
При аллергии на антибиотики назначаются макролиды (Эритромицин, Азитромицин, Джозамицин).
Женщинам может быть рекомендован Гексикон. Это вагинальные свечи, оказывающие антисептическое и дезинфицирующее действие.
В некоторых случаях терапия дополняется стрептококковыми бактериофагами.
Для нормализации работы ЖКТ назначаются пробиотики (Линекс, Бифидумабактерин, Ацилакт, Аципол).
Сорбенты (Атоксил, Полисорб, Альбумин, Смекта) способствуют качественному выведению токсинов.
Применение иммуностимуляторов (Лизобакт, Имунорикс, Имудон) позволяет улучшить состояние иммунитета и усилить действие антибиотиков.
При возникновении аллергических реакций назначаются антигистаминные препараты (Цетрин, Кларитин).
Если существует опасность инфицирования ребенка при родах, то терапия антибактериальными препаратами выполняется непосредственно в процессе родоразрешения, а также после разрыва околоплодного пузыря и отхождения амниотической жидкости. Более раннее лечение не будет достаточно эффективным, патогенные микроорганизмы продолжат размножение. Для санации влагалища могут быть назначены вагинальные таблетки и свечи (Флуомизин, Тержинан, Гексикон).
Лечение стрептококка агалактии проводится под контролем врача. Все рекомендации должны выполняться. Санация влагалища или терапия антибиотиками помогают уменьшить риск заражения ребенка.
Размножение условно-патогенных бактерий приводит к выделению токсических веществ, которые с током крови разносятся во все системы и органы.
Они воздействуют на защитные способности организма, вызывая аутоиммунные заболевания:
У беременных, имеющих высокий титр концентрации стрептококков агалактия в мазке или моче, при отсутствии своевременной терапии могут возникнуть серьезные осложнения.
Чаще всего развивается:
У грудного ребенка заражение стрептококком агалактия может вызвать не менее тяжелые последствия.
Возможно:
Летальный исход отмечается более чем в половине случаев заражения новорожденных.
Стрептококк у мужчин выявляется чаще всего в мазке из зева, носа или во время анализа мочи. Он выступает нормальным обитателем носовой полости, рта и кишечника, в связи с этим диагностическую ценность играет комбинация его высокого титра с клиническим проявлением инфекционного заболевания.
Streptococcus agalactiae у мужчин (или по-другому стрептококк агалактия) является условной патогенной бактерией, относящейся к группе гемолитических стрептококков. В норме данный микроскопический организм имеется в человеческом теле в малом количестве, но не вызывает болезни и никак не угрожает здоровью.
Род стрептококков сегодня насчитывает свыше двадцати видов бактерий. Одна часть этих микроскопических существ является представителями здоровой микрофлоры человека, а другая вызывает заболевания.
Сами бактерии имеют микроскопические размеры, у них шаровидная форма, они достаточно длительное время сохраняются в пыли, на различных предметах, могут переносить низкие температуры, а при температуре более пятидесяти шест градусов погибают лишь через тридцать минут.
Стрептококковую инфекцию вызывают бактерии данной группы, которые способны разрушать эритроциты, вызывая в человеческом организме воспалительный процесс. Streptococcus agalactiae у мужчин может доставлять неприятности абсолютно по тем же причинам, что и у дам.
В большей степени все, как правило, напрямую зависит от гормонального фона, а также от способности организма человека противостоять инфекции. Главной опасностью для здоровья человека при развитии стрептококковой инфекции служат яды с токсинами, которые выделяются болезнетворными микроорганизмами при размножении. Возбудитель может попадать в мужской организм следующими способами:
- Передача паразита может осуществляться при питании зараженными продуктами.
- Проникновение нередко происходит на фоне интимного контакта. Половой партнер, передающий инфекцию, может быть носителем или больным. Стрептококк способен активно размножаться во влагалище женщин, а при интимном контакте патогены попадают на половой орган мужчины. Также стрептококки способны размножаться в уретре.
- Алиментарным способом. Заражение часто наступает из-за нарушения правил личной гигиены. Стрептококки из прямой кишки попадают на половые органы.
- Возбудитель может проникать внутрь организма при стоматологическом осмотре либо хирургическом вмешательстве, если таковые осуществляются с применением инструментов, не прошедших необходимую дезинфекцию.
- Если инфекция у собеседника локализована в дыхательных путях, заразиться можно при поцелуе, чихании или кашле больного (слюна должна попасть на кожу или в дыхательные пути здорового человека).
- Бытовой путь. Стрептококки способны длительное время жить на различных поверхностях. Поэтому заразиться можно, если пользоваться предметами быта (посудой, полотенцем, бельем) больного.
Для анализ на Streptococcus agalactiae у мужчин, как правило, берут следующие биологические материалы:
- Мазок из ротоглотки (при болезнях верхних дыхательных каналов).
- Мазок из уретры (при патологиях мочеполовой системы).
- Исследование мокроты из носа.
- Взятие соскоба поверхности кожи (при развитии рожистого заболевания).
Также проводятся следующие исследования:
- Сдача крови и мочи.
- Биохимическое исследование крови.
- Проведение бактериологического посева.
- Ультразвуковое исследование внутренних органов.
- Проведение рентгенографии легких и электрокардиографии.
Лечение Streptococcus agalactiae у мужчин сводят к уничтожению ее источника. Курс терапии стрептококка, как правило, основывается на использовании антибиотиков пенициллиновой группы, а также препаратов, которые укрепляют иммунитет. На период лечения рекомендуют правильно питаться, снизив физические нагрузки, ведя здоровый образ жизни и соблюдая гигиену.
Для общего лечения Streptococcus agalactiae у мужчин используется «Бензилпенициллин», «Феноксиметилпенициллин», «Амоксициллин», «Аугументин», «Азитромицин», «Цефуроксим», «Цефтриаксон», «Цефотаксим», «Кларитромицин» и «Эритромицин». В рамках местной терапии применяют «Биопарокс», «Шексорал» или «Хлоргексидин». Любые назначения выполняет доктор, самолечением заниматься не рекомендуется.
В целях укрепления иммунной системы и стимулирования работы организма при инфекционном заболевании часто назначаются «Иммунал», «ИРС-19», «Имудон», «Имунорикс», «Лизобакт». Природным иммуностимулятором выступает аскорбиновая кислота, большое количество которой присутствует в шиповнике, лимоне, киви, клюкве, облепихе, смородине, петрушке, калине.
При использовании антибактериальных препаратов микрофлора, которая необходима для нормального функционирования системы пищеварения, обычно значительно угнетается. В целях ее восстановления в обязательном порядке назначают прием пробиотиков:
- «Аципол».
- «Бифидумабактерин».
- «Бифиформ».
- «Линекс».
У мужчин Streptococcus agalactiae group B (группы В) — выявляется редко. В основном, он обнаруживается у новорожденных, беременных и рожениц, вызывая во всех случаях (особенно у младенцев) тяжелые заболевания.
Мужчины могут им заразиться при половом контакте. Эти бактерии отравляют мужской организм разными ядами и ферментами, являющимися продуктами их жизнедеятельности.
Этими элементами усложняется течение болезни, а также вызывается немалое количество малоприятных проявлений.
Для вывода из организма токсинов бактерий необходимо выпивать много жидкости (около трех литров в сутки), полоскать ротоглотку раствором фурациллина, либо также подойдет слабо-соляное средство. Из препаратов для вывода патогенов из организма можно выделить «Атоксил», «Альбумин» и «Энтеросгель».
Применение антибактериальных лекарств иногда сопровождается некоторыми аллергическими реакциями. Чтобы они не переросли в осложнение, назначают антигистаминные средства:
- «Кларитин».
- «Супрастин».
- «Цетрин» и другие.
В целях облегчения симптоматики при наличии Streptococcus agalactiae в мазке у мужчин назначаются различные препараты (по показаниям). При возникновении тошноты и рвоты прописывают «Мотилиум», «Пипольфен», «Церукал».
При повышенной температуре требуются прохладные компрессы на лоб, на шею или в области подмышек. Среди препаратов стоит выделить «Парацетамол», «Ибупрофен».
При заложенности носа подойдут сосудосуживающие лекарства «Нокспрей», «Фармазолин» и их аналоги.
Направление на прохождение микробиологического посева и изучение микрофлоры мочеполовых каналов у мужчин доктор дает в том случае, если возникают симптомы раздражения в уретре. Представителями здоровой мужской микрофлоры являются: стрептококки, пептококки, микрококки, бациллярные микроорганизмы, стафилококки и лактобактерии.
Количество каждого вида микроорганизмов в пределах нормы может указывать на здоровье мочеполовой мужской системы. Если анализ показал, что Streptococcus agalactiae содержится в количестве 10 в 4 степени КОЕ/мл — это норма. Появление патогенных микроскопических организмов либо значительный рост численности какого-либо из участников биоценоза сообщает о сбоях в иммунитете или заболевании.
Мазок берется после специальной подготовки с помощью стерильного тампона. Его доставляют в лабораторию не позже двух часов с момента забора анализа.
В результате анализа он может насчитывать количество колониеобразующих единиц до десяти в пятой степени от общего числа микроскопических организмов.
Отсутствие патогенных представителей гонококка, трихомонады в сочетании с присутствием нормальных представителей в приемлемых соотношениях свидетельствует об отсутствии дисбактериоза и хорошем состоянии иммунитета.
Что значит Streptococcus agalactiae в мазке у мужчин?
Если в мазке обнаружен стрептококк выше нормы, а на фоне этого дополнительно присутствует симптоматика раздражения и нагноения, то можно предположить, что в организме зародилась стрептококковая инфекция.
Упомянутые ранее пептококки выступают аналогами лактобактерий нормального женского биоценоза.
Пептококки у мужчин также представляют стрептококки, которые способствуют восстановлению организма и поддержке нормального уровня кислотности.
Возрастание числа стрептококков прочих видов (патогенных в том числе) сообщает о присутствии источника инфекции или воспалительном процессе непосредственно в исследуемом органе. Причинами возникновения стрептококковой агалактии в мазке из уретры у мужчин, как уже отмечалось ранее, бывает ослабленный иммунитет, несоблюдение гигиены, половой акт с больным партнером.
Развитие очагов хронических инфекций в организме, например, фарингит, может спровоцировать болезни, которые вызывает стрептококк у взрослых в различных органах или системах. В особенности это может проявляться при ослаблении иммунитета на фоне переохлаждения, гиповитаминоза, при сахарном диабете, гипотиреозе.
Легкомысленное отношение к выбору полового партнера и к личной гигиене зачастую приводит к тому, что стрептококк начинает активно размножаться в половых органах мужчин и в уретре. Мазок пациента в таком случае будет указывать на стрептококк в качестве ведущего микроорганизма.
Антибактериальные препараты убивают не только патогенные бактерии, но и полезные.
Поэтому употребление антибиотиков в период лечения инфекционных патологий любой локализации требуется сочетать с пробиотиками, противогрибковыми средствами и пребиотиками.
Попадание на слизистую возбудителя половых инфекций тоже ведет к нарушению иммунитета, а вместе с тем к дополнительному обсеменению стрептококками.
Что означает Streptococcus agalactiae у мужчин 10 в 6 степени? Об этом далее.
Нормальное содержание в моче Streptococcus agalactiae у мужчин — 10 в 4 степени КОЕ/мл.
Увеличенная концентрация бактерий в урине выявляется при наличии инфекции или по причине некорректного забора биологического материала.
Рассматриваемые патогенные возбудители активно начинают развиваться в периоды ослабления иммунитета, во время пребывания пациента в стрессовом состоянии или в качестве сопутствующего заболевания.
Таким образом, высокая концентрация таких бактерий в анализе мочи может свидетельствовать о наличии в мужском организме стрептококковой инфекции. Возбудителем вызывается целый ряд серьезных заболеваний, которые затрагивают многие органы с системами. Недуги, которые спровоцированы этим микроорганизмом, пациенту доставляют дискомфорт. В отдельных случаях они могут даже угрожать жизни.
Источник: https://FB.ru/article/448366/streptococcus-agalactiae-u-mujchin-opredelenie-provedenie-analizov-prichinyi-i-lechenie
Род стрептококков насчитывает свыше 20-ти видов бактерий.
Часть таких микроорганизмов являются представителями нормальной микрофлоры человека, часть – вызывают заболевания (стрептококковую инфекцию), патогенны для организма.
Сами бактерии очень маленькие, имеют шаровидную форму, достаточно продолжительное время сохраняются в пыли, на предметах, переносят низкие температуры, в течение получаса погибают при 56°С.
Streptococcus mitis, представитель зеленящих стрептококков, в норме населяет переднюю уретральную часть у мужчин с частотой выявления порядка 25%.
В этой же области могут обнаруживаться• эпидермальный стафилококк (50-100%);• сапрофитный стафилококк (25%);• энтеробактерии (кишечная палочка E.Coli) – 25%;• синегнойная палочка (Pseudomonas aeruginosa) – до 5%;• фекальный энтерококк – 25%;• протеи (Proteus sp.
) – 25%;• коринебактерии (Corynebacteria) – 25%;• нейссерии (Neisseria sp.) – 25%;
• бактероиды (Bacteroides sp.) – 25%.
Уретральная микрофлора мужчин не зависит от возраста, но меняется при воздействии иных факторов. Некоторые микроорганизмы «населяют» уретру постоянно, некоторые – короткое время. В отличие от женской, мужская уретральная микрофлора не несет каких-либо специфических функций.
Отдельно выделяют так называемую транзиторную микрофлору (иначе называемую условно-патогенной).
К ней относятся микроорганизмы, для которых нетипично в норме постоянное нахождение у человека и которые провоцируют воспаление при благоприятных обстоятельствах, могут передаваться при сексуальном контакте.
Как правило, такие бактерии живут в урогенитальном тракте недолго, устраняясь защитными механизмами организма. У женщин – это кислая влагалищная среда, микрофлора лактобациллярная.
• фактор простаты противомикробный – представляет собой цинк-пептидный комплекс, обладающий антимикробными свойствами, вырабатывается предстательной железой (в простатическом секрете содержание цинка превышает его количество в иных органах в сто раз).
Транзиторная микрофлора при нарушении работы подобных механизмов приводит к развитию инфекционного процесса – стрептококковой инфекции. В случае генитально-орального контакта возможно инфицирование органов мочеполового тракта респираторными микроорганизмами (обитателями верхних дыхательных путей, полости глотки, рта), например, таким как бета-гемолитический стрептококк группы А.
https://youtube.com/watch?v=xm3PlRDlJdg
Еще один вид – стрептококк группы B (Streptococcus agalactiae) в норме не обнаруживается у мужчин, но часто выявляется у женщин (при этом он может вызывать инфекционные процессы, особенно опасные для новорожденных).
Также следует учитывать, что данный вид микроорганизмов у мужчин может развиваться при наличии иной инфекции полового тракта, поэтому наличие стрептококка группы B требует более тщательного обследования на предмет других возбудителей.
Основные пути передачи транзиторных, в том числе и стрептококковых, инфекций:• половой контакт (включая орально- и анально-генитальный);• от матери ребенку, внутриматочно, через кровь, при прохождении родовых путей;• при трансплантации органов.
Стрептококк у мужчин может быть причиной таких проблем, как:• уретрит (воспалительное поражение уретры);• баланит, баланопостит (головки, крайней плоти);• простатит (предстательной железы);• эпидидимит (придатка яичка);
• ухудшения качества спермы и пр.
Инфекция развивается в результате активизации транзиторной микрофлоры:• на фоне снижения иммунитета (при ВИЧ, после тяжелых болезней);• наличии хронических патологий различной природы (например, при диабете);• при простатите хроническом, предположительно из-за снижения в простатическом секрете содержания цинка;• при перенесении половых инфекций ранее, приведших к рубцеванию слизистой органов урогенитального тракта и нарушении вследствие этого местного иммунитета;• при ожоге уретры из-за злоупотребления антисептиками и т.д.
Лечение стрептококка у мужчин определяется видом микроорганизма и наличием клинических проявлений заболевания.
Наиболее часто стрептококки-представители транзиторных инфекций, попадая в органы урогенитальной системы, присутствуют в них всего несколько часов/недель и уничтожаются защитными силами организма (так называемое временное носительство). Выявление стрептококка в этот период при отсутствии клинических проявлений не является показанием к терапии. Однако, следует учитывать, что при временном носительстве весьма вероятно заражение полового партнера.
Стойкое носительство характеризуется тем, что микроорганизм в небольшом количестве присутствует постоянно в урогенитальной системе (симптомов при этом не отмечается), а в случае «сбоя» в организме проявляется бурной воспалительной реакцией. Инфицирование полового партнера в такой ситуации также возможно.
Выявление стрептококка, подтверждающее стойкое носительство последнего, при умеренно выраженных изменениях в простате – повод для более тщательной диагностики и лечения.Если организм перестает сдерживать рост стрептококков, возникают процессы воспаления, симптомы которых зависят от локализации.
• выделения из уретры.
Диагностика стрептококка в органах мочеполовой системы у мужчин включает:• анализы общие мочи и крови;• исследование мазков, секрета простаты методом полимеразной цепной реакции (при временном носительстве только ПЦР может выявить возбудителя);• культуральный посев (выделений, секрета простаты и др.);
• иные лабораторные методы (ИФА, РИФ и пр.) и инструментальные методы (УЗИ, МРТ, КТ) для исключения других причин наблюдаемых симптомов – нестрептококковых инфекций, опухолевых образований и т.д.
Необходимость лечения стрептококка определяется выраженностью симптомов. При отсутствии последних (выявление стрептококка произошло случайно во время рутинного обследования) применяется выжидательная тактика, при временном носительстве часто происходит самопроизвольное исчезновение микроорганизма.
Если же стрептококк, не относящийся к представителям нормальной микрофлоры, обнаружился на фоне жалоб на проблемы о стороны урогенитального тракта, проводят специфическую терапию антибиотиками. Предварительно необходимо определить чувствительность обнаруженных патогенных микроорганизмов к тем или иным антибактериальным препаратам.
Чаще всего используются представители пенициллинового (например, ампициллин), макролидного ряда, фторхинолонов. У больных со стрептококковой инфекцией урогенитального тракта и аллергией на пенициллины могут назначаться такие лекарства, как клиндамицин, цефазолин.
К сожалению, в последнее время часто наблюдаются случаи лекарственной устойчивости стрептококковой инфекции. При неэффективности назначенного антибиотика назначают новый препарат с учетом чувствительности.
Важно принимать во внимание высокую вероятность смешанной инфекции, особенно при выявлении у мужчин Streptococcus agalactiae. В этом случае может потребоваться лечение несколькими препаратами.
Врач может порекомендовать дополнительно к основному терапевтическому курсу:• физиопроцедуры;• массаж – при воспалении предстательной железы;• иммуномодулирующие средства;• ферменты;• местное лечения (вливания в уретру растворов различных лекарственных препаратов);
• средства народной медицины (ванночки на основе отваров лекарственных трав, например, ромашки, прием клюквенного сока и т.п.) и др.
Отсутствие адекватной терапии стрептококковой урогенитальной инфекции у мужчин может стать причиной:• перехода заболевания в хроническую форму;• распространения воспалительного процесса на иные органы и ткани (поражения яичек, семенных пузырьков, придатков);• бесплодия и импотенции и пр.
Инфицирование женщин во время беременности может вызвать серьезные патологии у новорожденных, например, развития сепсиса – заражения крови.
Поделиться: